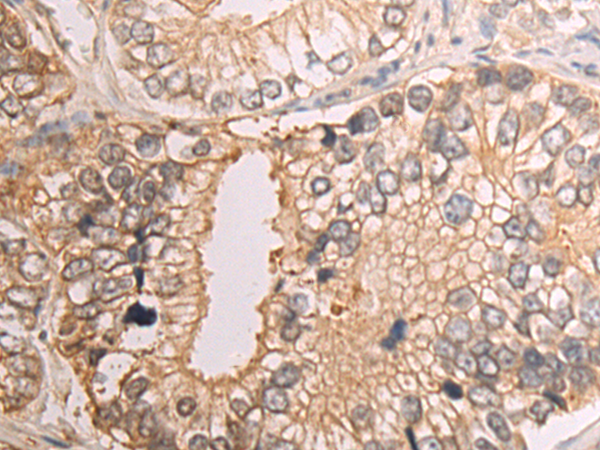
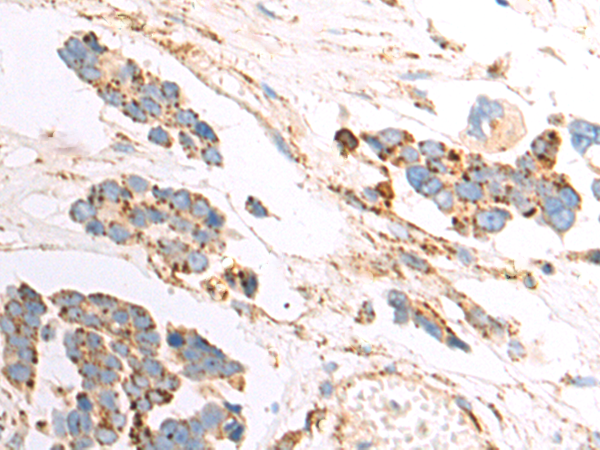
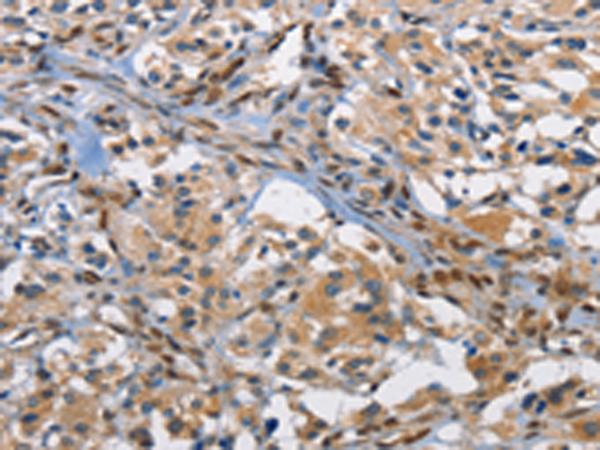

-
分类: 科研抗体货号: P00274别名: CLEC1; CLEC-1应用: WB,IHC反应种属: Human
-
分类: 科研抗体货号: P00239别名: CTSU; CATL2; CTSL2应用: WB,IHC反应种属: Human, Mouse
-
分类: 科研抗体货号: P00273别名: CaCC; CaCC2应用: WB,IHC反应种属: Human, Rat
-
分类: 科研抗体货号: P00237别名: CPSB, ACC-4, ACC-5, minichain应用: WB,IHC反应种属: Human, Mouse, Rat
-
分类: 科研抗体货号: P00270别名: M1; HM1; M1R应用: WB反应种属: Human, Mouse, Rat
-
分类: 科研抗体货号: P00232别名: CAP102应用: WB,IHC反应种属: Human, Mouse
-
分类: 科研抗体货号: P00269别名: p55; AP-1; C-FOS应用: WB,IHC反应种属: Human, Mouse, Rat
-
分类: 科研抗体货号: P00298别名: EBS7; GP27; MER2; RAPH; SFA1; PETA-3; TSPAN24应用: WB,IHC反应种属: Human, Mouse, Rat
-
分类: 科研抗体货号: P00264别名: GP39; ASRT7; GP-39; YK-40; YKL40; CGP-39; YKL-40; YYL-40; HC-gp39; HCGP-3P; hCGP-39应用: WB,IHC反应种属: Human, Rat
-
分类: 科研抗体货号: P00296别名: CD355应用: WB,IHC反应种属: Human

鄂公网安备42018502007531号
鄂公网安备42018502007531号

